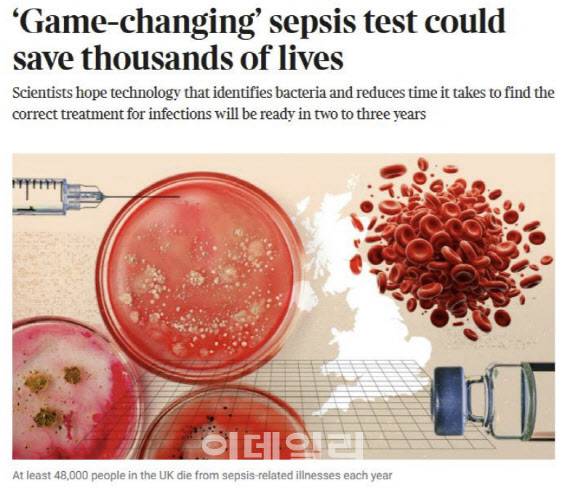
더 타임즈가 보도한 퀀타매트릭스 패혈증 진단 기술.(출처= 더 타임즈)

해외 언론이 퀀타매트릭스 기술 조명하는 이유
[이데일리 석지헌 기자] 진단기업 퀀타매트릭스(317690)가 항생제를 빠르게 찾아주는 기술을 세계적 과학저널 ‘네이처’(Nature) 본지에 게재한 이후 해외 언론들 관심이 이어지고 있다. 이번 논문에 실린 기술이 수천 명의 패혈증 환자 생명을 구할 수 있을 것으로 전망하면서 사회적 의미가 적지 않음을 시사했다.
31일 업계에 따르면 영국 일간지 ‘더 타임즈’(The Times)와 영국 공영 방송사 BBC의 라디오, 영국 일간 경제지 ‘파이낸셜 타임즈’(FT), 미국 과학전문매체 ‘라이브사이언스’ 등 해외 언론사 10여 곳은 최근 네이처에 게재된 패혈증 진단 기술을 소개하는 기사를 보도했다. 이 중 주요 매체들은 논문의 교신저자이자 연구책임자인 권성훈 퀀타매트릭스 대표와 제1저자이자 주연구원인 김태현 서울대 박사 인터뷰를 통해 패혈증 진단 시간을 단축할 수 있는 기술에 대해 구체적으로 질문했다. 이는 최근 보도자료를 외신 보도로 포장해 업계 질타를 받은 국내 의료 인공지능 기업 사례와는 다르다.
앞서 네이처 본지는 24일(현지시간) 퀀타매트릭스의 올인원 항생제 감수성 검사 솔루션 ‘uRAST’(Ultra-Rapid Antimicrobial Susceptibility Testing) 원천기술에 대한 임상시험 결과를 담은 논문을 소개했다. 논문명은 ‘Blood culture-free ultrarapid antimicrobial susceptibility testing’(혈액 배양 없는 초고속 항생제 감수성 검사)이다. 논문에 따르면 uRAST 기술을 포함한 퀀타매트릭스의 항생제 검사 솔루션은 기존 72시간 이상 걸리던 항생제 찾는 시간을 13시간 이내로, 약 5분의 1로 단축시킨 것을 확인했다. 이는 세계 최단 시간이다. 검사 정확도는 94.9%로 기존 검사법과 높은 일치 결과를 보였다.
더 타임즈는 ‘판도를 바꾸는 패혈증 검사, 수천 명 목숨 구한다’는 제목의 기사에서 “과학자들은 이 기술이 패혈증 감염에 대한 올바른 치료법을 찾는 데 걸리는 시간을 극적으로 단축할 수 있으며, 잠재적으로 매년 수천 명의 생명을 구할 수 있다고 말했다”고 보도했다. 보도에 따르면 영국에서는 매년 최소 24만5000명의 패혈증 환자가 발생하고 있으며 최소 4만8000명이 패혈증 관련 질환으로 사망한다. 해당 언론과의 인터뷰에서 김태현 박사는 이번 패혈증 진단 기술이 절대적인 ‘게임체인저’가 될 잠재력이 있다고 했다.
권성훈 대표를 인터뷰한 BBC 라디오는 퀀타매트릭스와 서울대 연구진이 어떻게 혈액배양 검사 단계를 단축할 수 있었는지 집중적으로 질문했다. 혈액 내 극소수의 균의 존재를 감지하는 것 혈액배양은 짧게는 하루, 길게는 7일까지도 소요된다고 알려진다. 퀀타매트릭스는 이 단계를 자체 개발한 혁신기술로 대체해 60분 이내로 줄였다. 현재까지 혈액배양 단계를 생략한 기술을 개발한 기업은 없었다.
권 대표는 “생체 내에서 병균을 감지하는 단백질 조각을 자성 나노입자에 코팅해 균을 걸러내는 기술을 통해 획기적으로 단축할 수 있었다”며 “뿐만 아니라 나노 기술과 분자 ·마이크로 기술, 인공지능(AI) 등 여러 이종 기술을 융합한 결과 기술적 난제를 해결할 수 있었다”고 설명했다.
FT는 빠른 항생제 진단 기술은 여러 생명을 구할 수 있지만, 의료 시스템이 이러한 혁신 기술을 받아들이기엔 아직 역부족이라는 점을 지적했다. 보도에서는 영국 국민보건서비스(NHS)의 ‘집중치료’ 부문 컨설턴트이자 세계패혈증연맹 창립자인 론 다니엘 교수의 말을 인용, “영국 국민보건서비스(NHS)는 현재 항생제 처방을 지연시키는 여러 과정들을 통합한 더 혁신적인 기술들을 받아들이는 방법에 대해 고민해야할 것”이라고 분석했다.
“패혈증 사망률 절반 이하로 ‘뚝’”
외신들이 이번 패혈증 진단 기술에 주목하는 이유는 이 기술이 상용화될 경우 적지 않은 패혈증 환자들 목숨을 구할 수 있다는 점에서 사회적 의미가 크기 때문으로 분석된다.
패혈증은 핏속 병균이 번식해 몸 전체에 감염 증상이 발생하는 질환이다. 환자 생존율이 1시간 마다 9%씩 감소하는 병원 내 직접 사인 1위 중증 질병이며, 10명 중 2~5명은 사망에 이른다. 그만큼 촌각을 다투기 때문에 신속하게 환자에게 맞는 항생제를 찾는 것이 핵심이다.
패혈증 환자는 전 세계적으로 매년 4000만 명 이상에게서 발병하고 있다. 그 수는 갈수록 늘어날 전망이다. 항생제 남용으로 ‘슈퍼박테리아’로 불리는 항생제 내성균이 전 세계적인 문제로 떠오르면서다. 세계보건기구(WHO)에 따르면 슈퍼박테리아로 인한 사망자는 오는 2050년 연간 1000만 명에 이를 것으로 추산된다. 국내만 해도 패혈증 환자 수는 인구 10만 명 기준으로 2011년 3.7명에서 2021년 12.5명으로 4배 가까이 뛰었다.
이런 상황에서 빠르게 최적의 항생제를 찾아주는 기술은 1시간마다 사망률이 9%씩 상승하는 패혈증 환자들 목숨을 살릴 수 있다. 이번에 게재된 논문에 따르면 기존에 3일 걸리던 패혈증 검사 시간을 24시간으로 줄이기만 해도 패혈증 사망률은 절반 이하로 뚝 떨어진다.
여기다 퀀타매트릭스가 지난해 유럽에서 실시한 임상시험 결과에 따르면 기존 제품인 신속 항생제 감수성 검사 솔루션 ‘dRAST’를 사용하면 중증 패혈증 환자 사망률을 약 15% 감소시킬 수 있다. dRAST를 통해 신속하게 적정 항생제를 처방할 경우 패혈증 환자의 30일 내 사망률이 기존 24.4%에서 9.5%로 14.9%포인트(p) 감소한 것을 확인했다. dRAST는 기존 검사 시스템 대비 최대 17시간 단축할 수 있는 퀀타매트릭스의 대표 제품이다.
석지헌 (cake@edaily.co.kr)
Copyright © 이데일리. 무단전재 및 재배포 금지.
- ‘활·총·칼’ 돌풍 비결은…공정 협회·무한 경쟁·기업의 전폭 지원
- "남편 양복이 젖을 정도로"...'성추행 누명' 숨진 교사, 7년 뒤[그해 오늘]
- 김예지 “0점 쐈을 때는 정말…머스크는 왜 나를?” [파리올림픽]
- 삼성 한달 파업이 남긴 것…'무노동 무임금' 원칙 세웠다
- "집 비번 알려주고도, 오히려 미안하다고"… 청라 이재민의 '눈물'
- 한국 양궁, 사상 첫 올림픽 금메달 5개 싹쓸이...김우진 3관왕[파리올림픽]
- 두 딸 데리고 잠적한 아내, 5년 만에 나타나더니…“460만원 내놔”
- ‘성장’ 의심받는 엔터株, ‘대답’ 내놓은 하이브
- 하자 건수 부풀리고, 소송 부추기고…아파트 '브로커' 주의보
- [정치프리즘]특검·탄핵 밀어붙이는데 지지율은 침몰하는 민주당